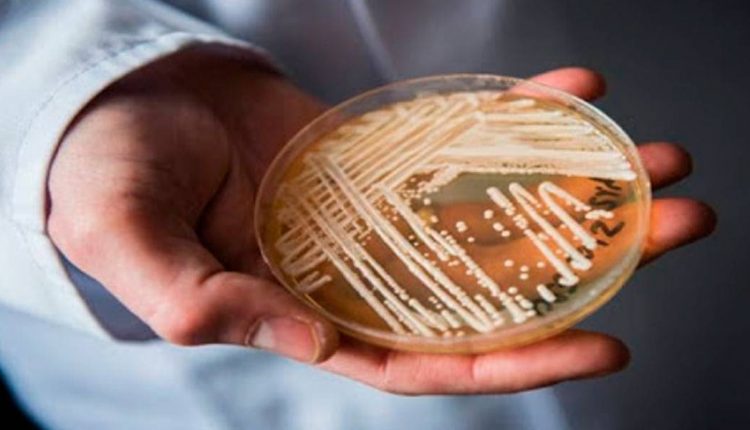

“Lascou foi tudo! Anvisa faz alerta sobre superfungo detectado em hospital particular de Salvador”
Tão achando pouco!
A Agência Nacional de Vigilância Sanitária (Anvisa) emitiu um alerta ontem (7) sobre uma investigação do primeiro caso positivo no país de Candida auris, fungo resistente a medicamentos que representa uma séria ameaça à saúde pública em virtude da taxa de letalidade próxima a 60%.
O fungo foi detectado na última sexta-feira (4) no cateter de um paciente internado em um hospital privado da capital baiana. Foram realizadas duas contraprovas, sendo uma no Laboratório Central de Saúde Pública da Bahia (Lacen-BA) e outra na Universidade de São Paulo, que é a referência nacional do Ministério da Saúde, testando positivo em todas as ocasiões.
Bicho forte da pêga:
De acordo com o alerta da Anvisa, o fungo apresenta resistência a vários medicamentos antifúngicos comumente utilizados para tratar infecções por Candida. Ele pode causar infecção em corrente sanguínea e outras infecções invasivas, sendo fatal, sobretudo, em pacientes com comorbidades. Também há uma propensão em causar surtos em decorrência da dificuldade de identificação oportuna pelos métodos laboratoriais rotineiros e de sua eliminação do ambiente contaminado.
Fungo Ninja; Difícil detecção e controle
A identificação desse fungo requer métodos laboratoriais específicos uma vez que a Candida auris pode ser facilmente confundida com outras espécies de leveduras, tais como Candida haemulonii e Saccharomyces cerevisiae. Além disso, pode permanecer viável por longos períodos no ambiente (semanas ou meses) e apresenta resistência a diversos desinfetantes, entre os quais, os que são à base de quartenário de amônio.
O fungo foi identificado pela primeira vez em 2009 no canal auditivo de uma paciente no Japão. Desde então, houve casos identificados em países como Índia, África do Sul, Venezuela, Colômbia, Estados Unidos, Israel, Paquistão, Quênia, Kuwait, Reino Unido e Espanha.
Fonte: Ascom Sesab











